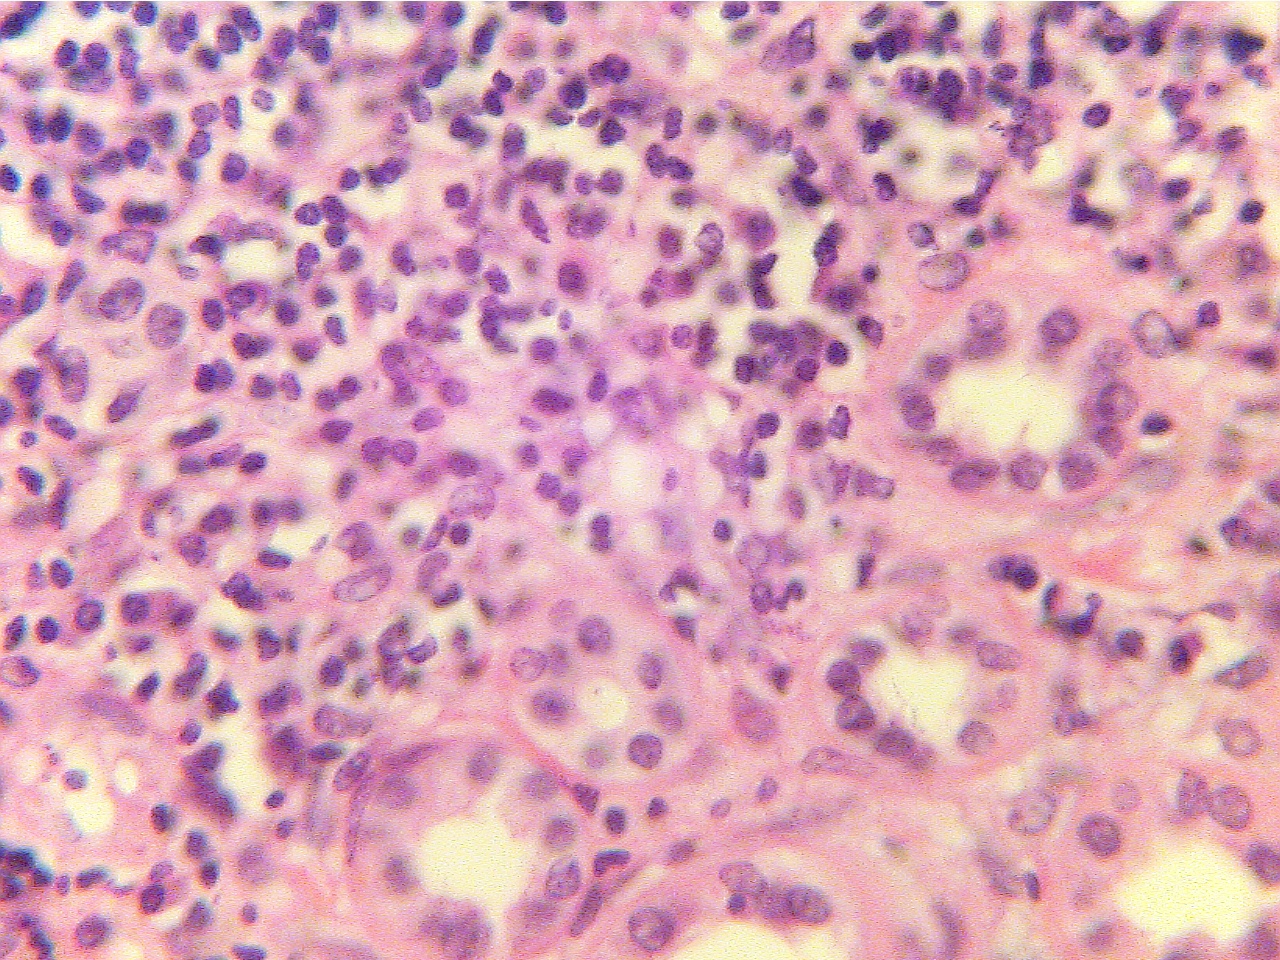

Return to Lab 07
Acute (Hematogenous) Pyelonephritis - (PH 1726)
(pp. 698-699)
(Be
able to identify this slide as abnormal; identify normal glomeruli, tubules, and
inflamed areas; and differentiate between this slide and slides showing normal
kidney.)
In pyelonephritis, infection of the kidney causes inflammation
and damage to the tubules. Note the scattered patches of inflammatory white
blood cells. Using high power, notice that the tubular cells have indistinct
outlines because they are damaged. The glomeruli appear normal. Compare
this slide with that of the normal kidney.
Pyelonephritis (100X2.8)
Pyelonephritis (400X2.0)

* Which of the 3 main processes in urine formation would be most affected
in this kidney? (pp. 661, 696)
Return to Lab 07
8Copyright
2001 - Augustine G. DiGiovanna - All rights reserved.
This material may not be reproduced or distributed in any form or by any means, or stored in any data base or retrieval system without prior written permission is obtained from Augustine G. DiGiovanna, Ph.D., Professor of Biology, Salisbury University, Salisbury, MD 21801.